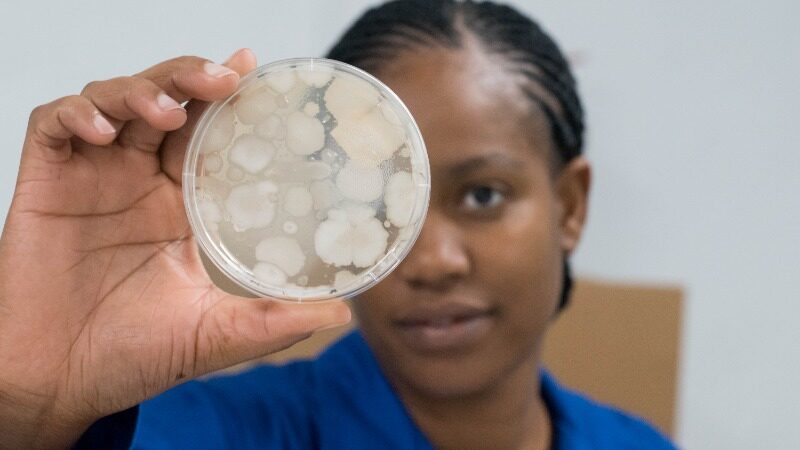

Services
Parasitology
Specialised monitoring for poultry and general veterinary samples.
While primarily used in poultry, these tests can also support broader veterinary and agricultural needs.
SMT VET provide an extensive range of methodologies, such as:
- Faecal Oocyst count (Unaccredited)
- Specific Gravity (Unaccredited)
- Faecal worm egg count (Unaccredited)
Not finding what you need?
Reach out to us. If a specific test is not listed, we may be able to source it, recommend alternative solutions, or explore it through our R&D department.

Why Choose SMT VET
Industry-Leading Speed
Results in as little as 3 days for positive release, consistently beating average turn-around times.
Trusted Accreditation
SANAS accredited and DAH approved, ensuring full compliance.
True Partnership
Nation-wide footprint with personal, expert support whenever you need it.
Get Started
Request a Quote Today
Fast, accredited testing tailored to your needs.
Tell us what you need tested and our team will guide you to the right methods. From food safety to water and environmental monitoring, we’ll provide a clear, competitive quote and outline the turnaround time.



